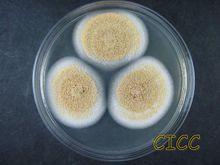
赭麴黴

生物特性
赭麴黴是一種產毒均,其分離培養常用察氏培養基;在穀物培養基中,以碎小麥為基質的產毒效果最好。生長條件一般產毒黴菌在25~28℃,高濕度、陰暗靜置條件下培養1~2周產毒效果較好。
赭麴黴
赭麴黴赭麴黴毒素
赭麴黴毒素是真菌毒素之一, 是由赭麴黴及青黴菌等產毒菌株侵染糧食、食品、飼料及其他農副產品後所產生的一種有毒代謝產物。赭麴黴毒素廣泛存在於各種食物中,穀物及其副產品、可可、咖啡、肉類、乳汁、乾果、調味品、酒類等中。赭麴黴毒素對人類及動物健康造成了很大的威脅, 它可以導致受試動物的腎萎縮、胎兒畸形、流產及死亡, 並具有高度的致癌性,國際癌症研究機構在1993年將赭麴黴毒素 A(OchratoxinA, OTA)定為人類可能的致癌物。因此赭麴黴毒素受到了全世界的廣泛關注。
 赭麴黴
赭麴黴赭麴黴毒素是 L-β-苯基丙氨酸與異香豆素的聯合,有 A、B、C、D 4 種化合物, 此外還有赭麴黴毒素 A 的一些代謝產物,如 4-R-羥化赭麴黴毒素、4-S-羥化赭麴黴毒素、10-羥化赭麴黴毒素、以及赭麴黴毒素 B 的代謝產物赭麴黴毒素β等,都是結構類似的化合物。這些物質在化學結構上只有細微差異,但在毒理學方面卻差別很大。其中赭麴黴毒素 A 分布最普遍,毒性最強,並且最容易檢出 。
盤點麴黴屬及其相關有性型的真菌
| 麴黴屬是叢梗孢目(Moniliales)叢梗孢科中的一屬。在自然界分布極廣,是引起多種物質霉腐的主要微生物之一。本期主要是盤點該屬及其相關。 |

